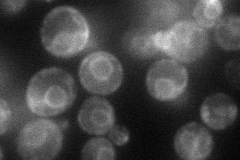
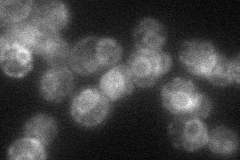
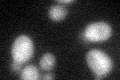

View description
Broad-specificity lysophospholipid acyltransferase, part of MBOAT family of membrane-bound O-acyltransferases; key component of Lands cycle; may have role in fatty acid exchange at sn-2 position of mature glycerophospholipids
Localization:
Intensity:
Fold change:
Significance:
-
C’ GFP library in SD

below threshold15.9 -
N' NOP1pr-GFP in SD
ER49.4453 -
N' TEF2pr-mCherry in SD
ER33.3897 -
N' NATIVEpr-GFP in SD

below threshold19.2829 -
N' TEF2pr-VC and Cyto-VN in SD

below threshold22.9292 -
C’ GFP library in SD+DTT
cytosol15.580.97No -
C’ GFP library in SD+H2O2

cytosol15.520.97No -
C’ GFP library in Starvation Media

cytosol17.161.07No -
C’ GFP library on the background of Pup2-DaMP

below threshold -
C’ GFP library on the background of CCT mutant

below threshold13.79790.867201No
